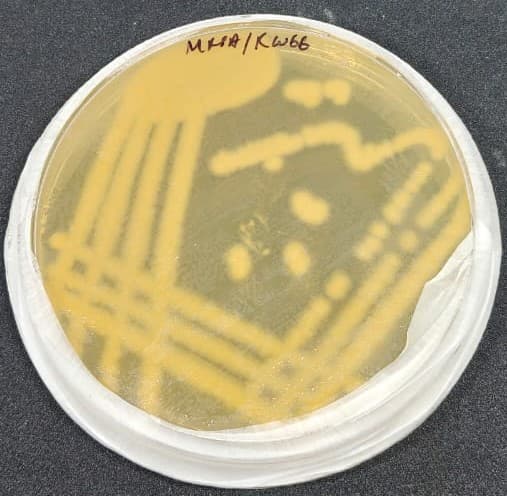
Exploring Microbial Diversity in Rice Wine Fermentation - 2
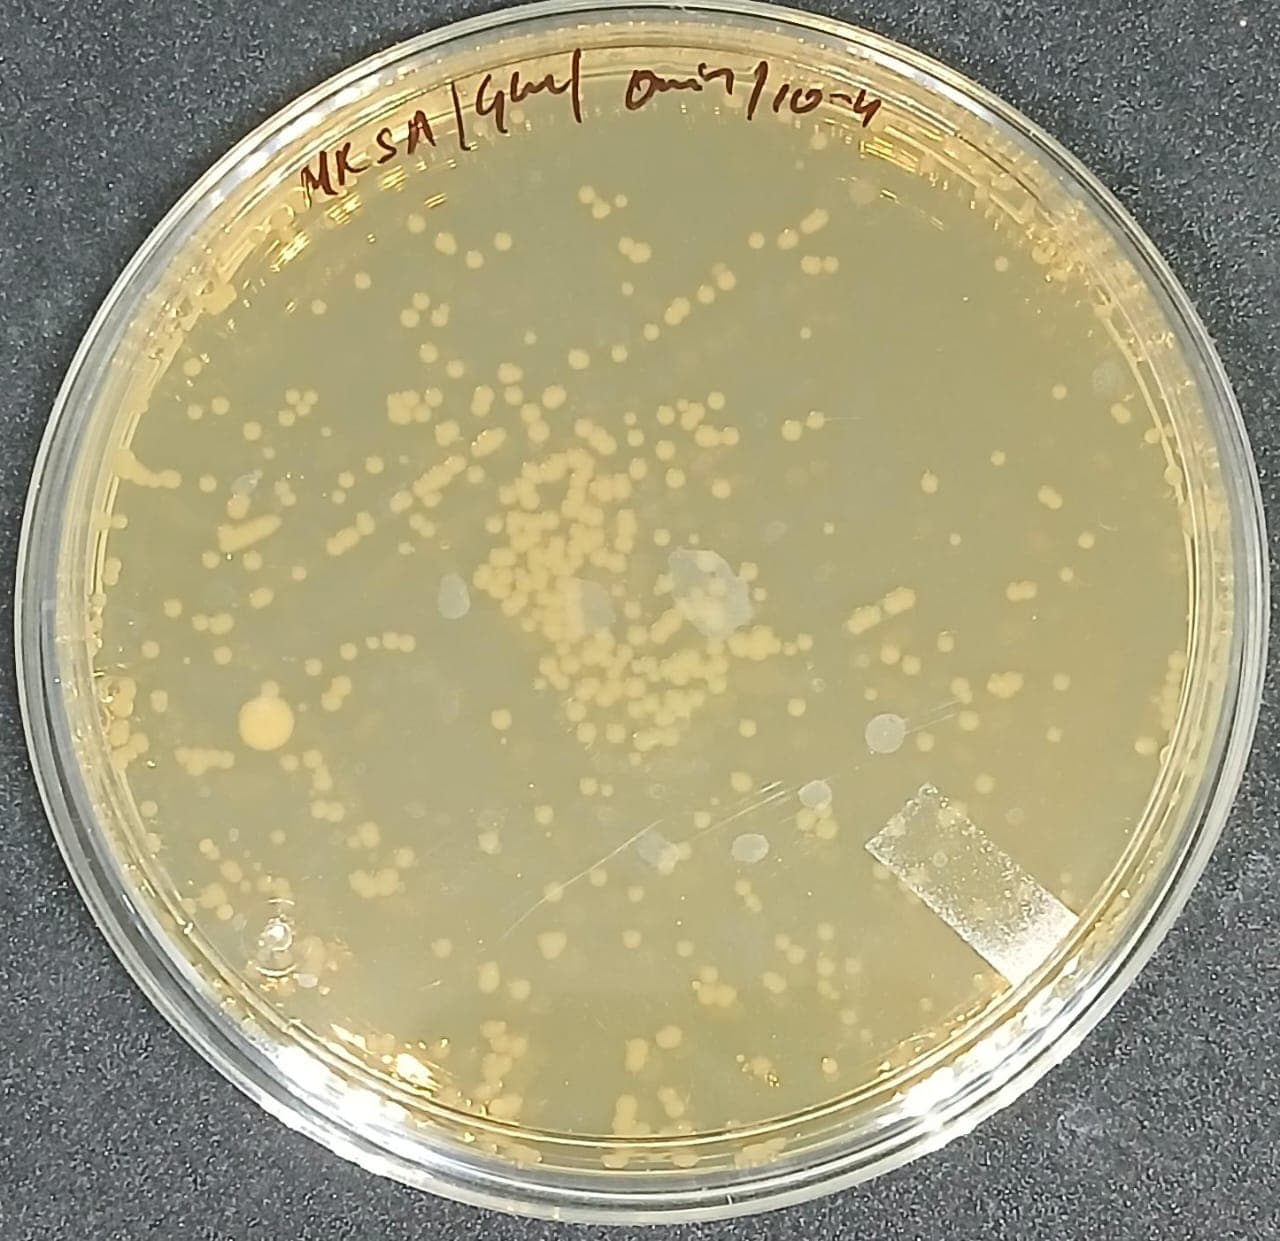
Exploring Microbial Diversity in Rice Wine Fermentation - 5
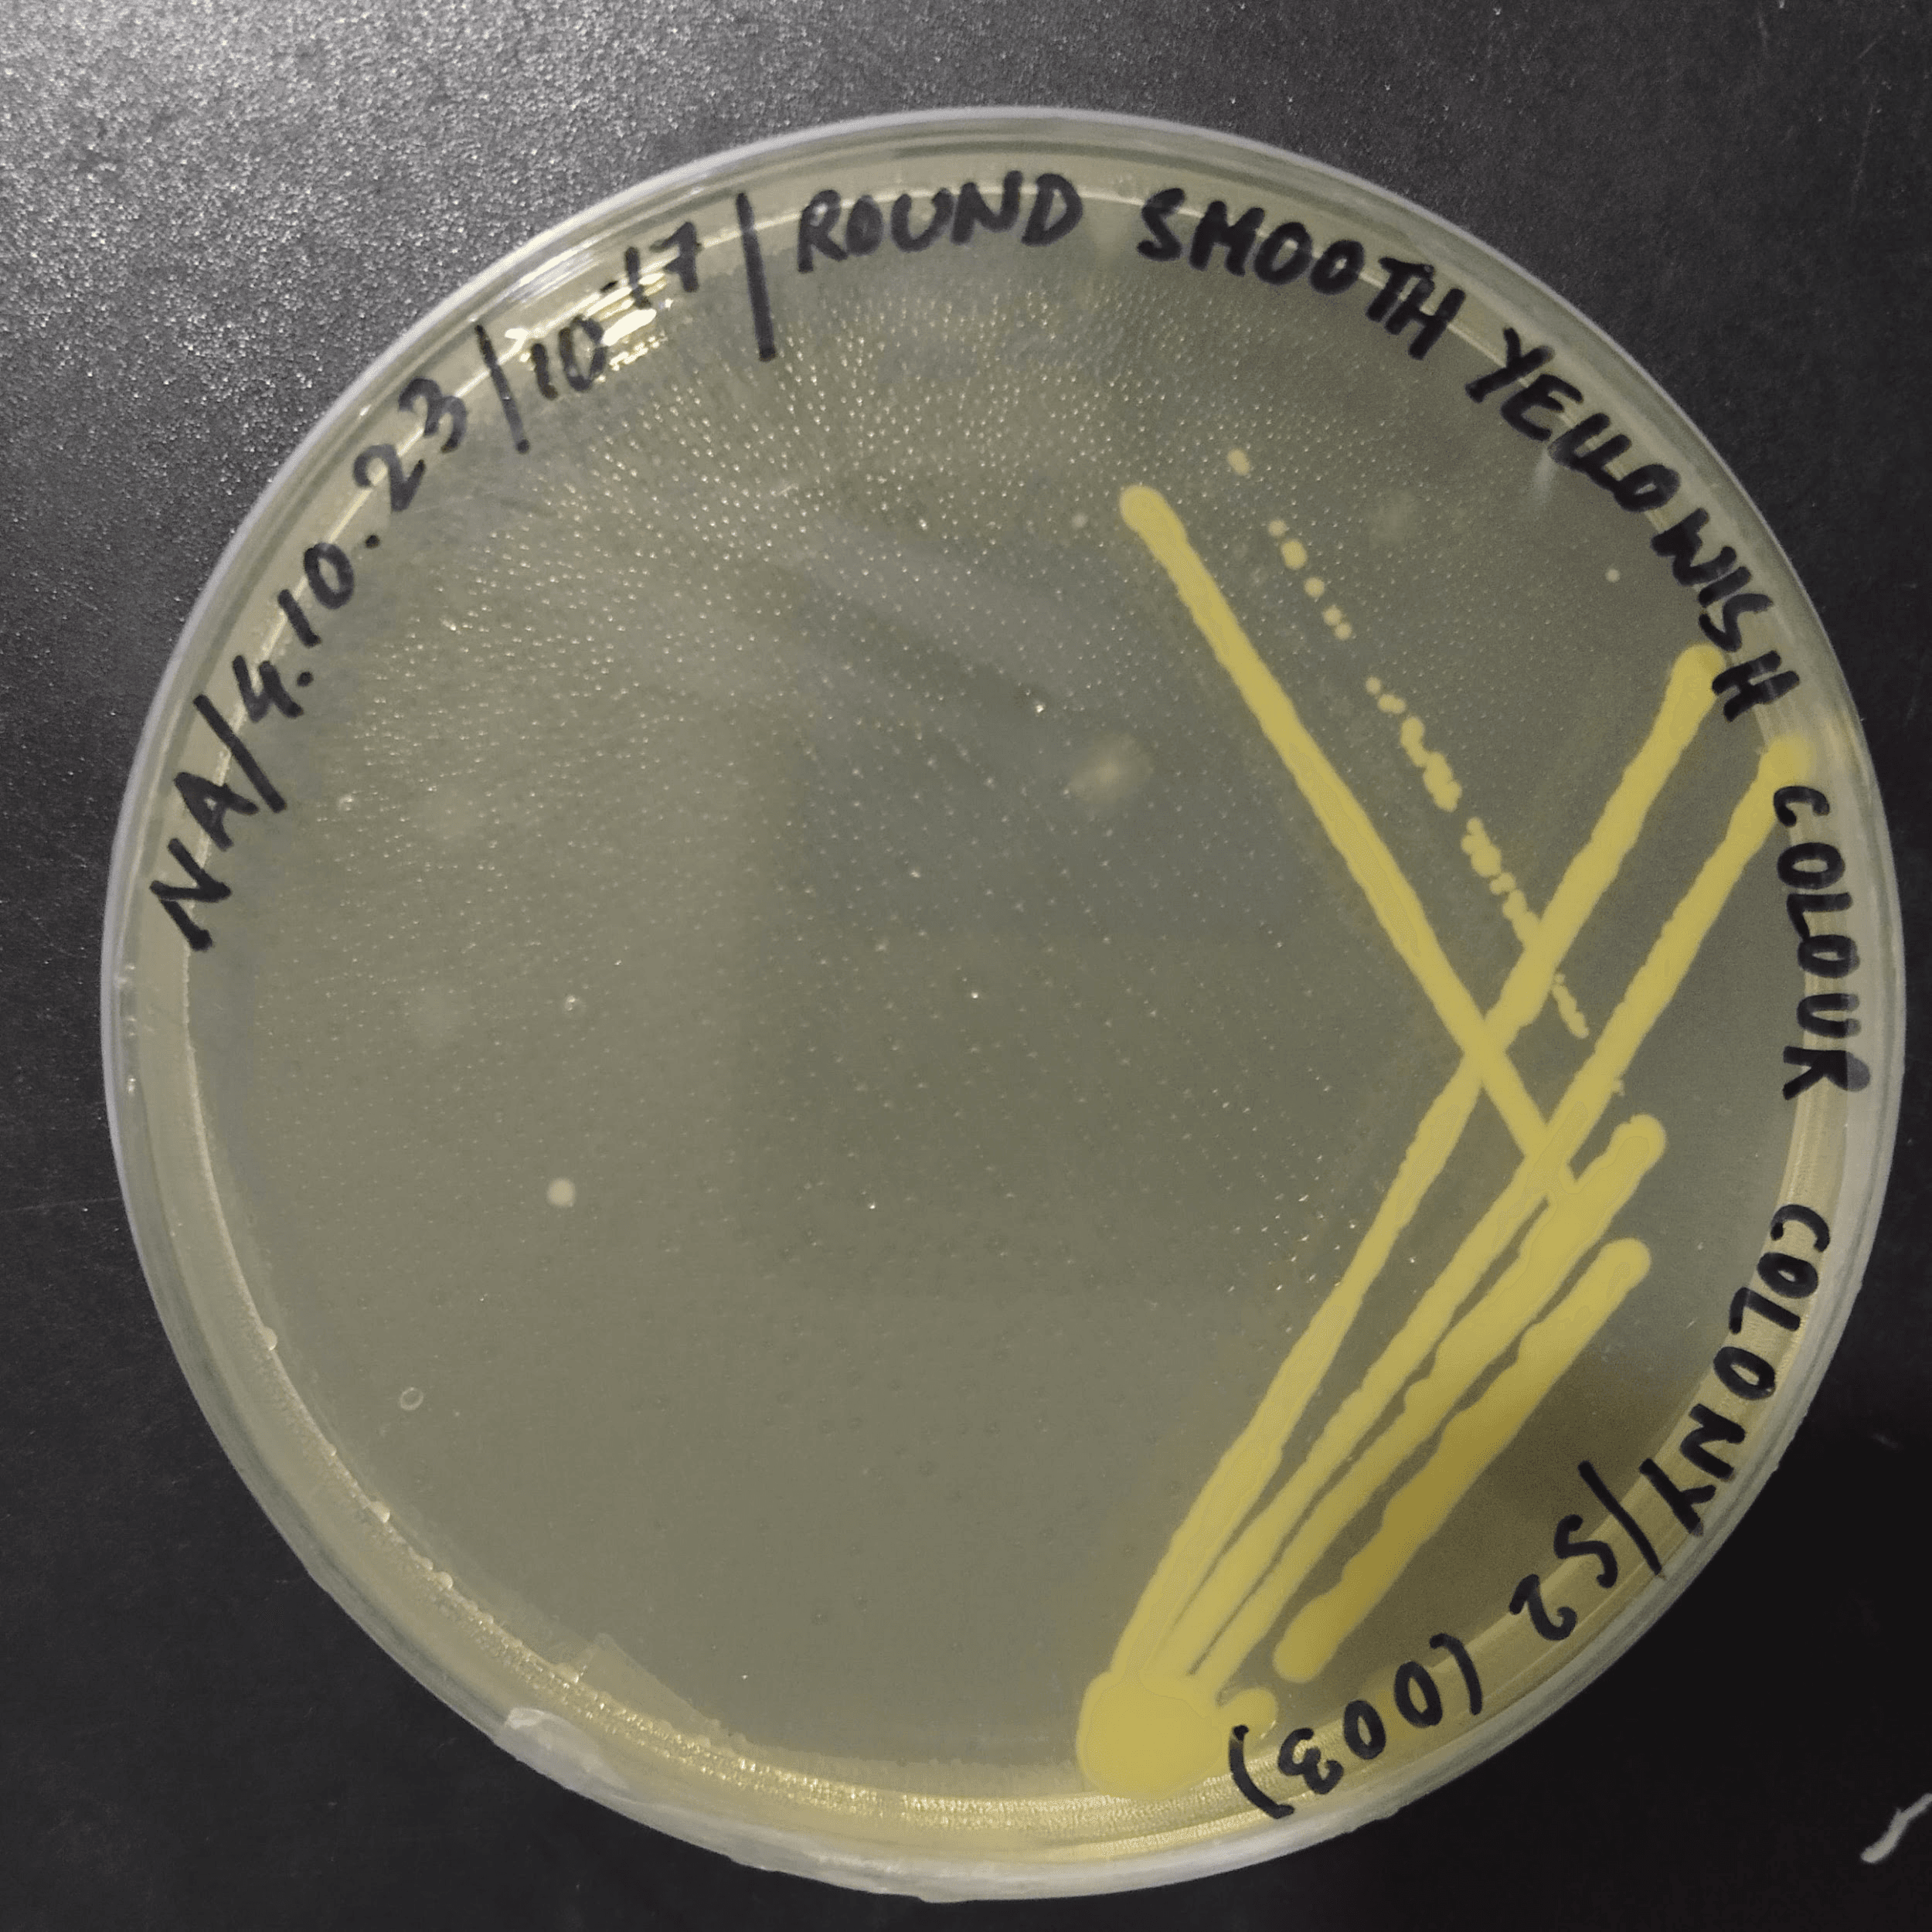
Bharalu Project: Exploring Microbial Diversity of the Bharalu River - 3
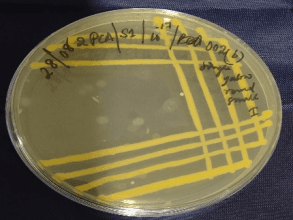
Bharalu Project: Exploring Microbial Diversity of the Bharalu River - 2

Research Excellence
At MR Biologist LLP, we bridge the gap between classroom learning and real-world research. Join our hands-on training and internship programs in biotechnology, molecular biology, and bioinformatics — designed to help you gain practical experience, build confidence, and prepare for your future in science.
At Mr Biologist, we stand at the forefront of scientific exploration, consistently striving to elevate the realms of possibility in the fields of Biotechnology and Bioinformatics. Our commitment to progress is unwavering, as we embrace and harness the power of the latest research technologies to drive innovation and transformation.
Our company serves as a beacon of advancement, combining cutting-edge research methodologies with a passionate team dedicated to shaping the future of these dynamic disciplines.
“We're not merely a company; we're a pioneering force that has embraced the spirit of exploration, rewriting the narrative of what's achievable in these fields.”

As an independent startup based in the Northeast, we take immense pride in the journey that has brought us to this point. Our presence in both Pune and Guwahati signifies our commitment to not only geographical expansion but also the expansion of possibilities within the biotech and bioinformatics domains.
Amrit Pritam Bhuyan is the founder and CEO of Mr Biologist LLP, an independent biotechnology and bioinformatics CRO based in Guwahati (Assam) with a branch in Pune.
Under his leadership since 2021, the company provides services in genome sequencing, molecular biology, bioinformatics analytics and microbial testing, with a mission to bring advanced biotech capabilities to the Northeast region.
Established as NorthEast India's first biotech and bioinformatics CRO
Set up main facility in Guwahati, Assam
Opened branch office in Pune for wider reach
Achieved 4.9 rating on Justdial with 27+ reviews
We provide comprehensive computational biology, genome sequencing, microbial services, and bioanalytical solutions to accelerate research and improve healthcare outcomes in Northeast India.
Advanced molecular docking for protein-ligand, protein-protein, DNA-protein, ligand-ligand interactions, plus molecular dynamics simulations.
Complete protein modeling services including structure prediction, refinement, validation, and functional analysis.
Comprehensive bioinformatics solutions for pathway mapping, network pharmacology, and phylogenetic analysis.
Comprehensive DNA barcoding for plants, bacteria, fungi, and insects, plus 16S/18S rRNA and ITS region metagenomics.
Complete genome sequencing, transcriptomics, and gene expression analysis for research and clinical applications.
Advanced gene quantification and validation using RT-PCR and sequencing technologies.
Comprehensive microbial isolation, identification, and antimicrobial susceptibility testing including biofilm analysis.
Advanced protein extraction, purification, and profiling using MALDI-TOF and Q-TOF mass spectrometry.
Detailed enzyme analysis including activity assays, optimization, and terminal sequencing.
Complete phytochemical screening using multiple assay methods including DPPH, FRAP, ABTS, TPC, and TFC.
Comprehensive in-vitro testing for various biological activities including cytotoxicity, anticancer, anti-diabetic, and neuroprotective studies.
Complete animal model studies for toxicological safety assessment including acute, sub-chronic, reproductive, and carcinogenicity testing.
Comprehensive profiling of vitamins and amino acids in food products and nutraceuticals.
Complete macronutrient composition analysis including fatty acids, proteins, carbohydrates, and fiber.
Trace element and mineral analysis using AAS and related advanced analytical techniques.
Advanced chromatographic and spectroscopic analysis for qualitative and quantitative determination.
Advanced molecular characterization using spectroscopic and imaging techniques.
Complete sample preparation and molecular biology services including extraction, PAGE, PCR, and primer synthesis.
We collaborate with leading laboratories and research institutions to deliver exceptional results in biotechnology and bioinformatics

Strategic partner in genomics and bioinformatics solutions

Collaborative partner in microarray technologies

Partner in advanced biotechnological research

Trusted partner in scientific testing and certification
Celebrating excellence and innovation in biotechnology and bioinformatics research

Biotechnology Industry Association
Recognition for outstanding contributions to biotechnology and bioinformatics research in Northeast India.

National Science Foundation
Awarded for innovative computational biology solutions and research excellence.

Environmental Research Council
Recognition for groundbreaking research in microbial diversity and environmental sustainability.

Startup India Initiative
Awarded to Mr Biologist for exceptional startup growth and innovation in the biotech sector.

National Academy of Sciences
Honoring significant contributions to scientific research and development in biotechnology.

Agricultural Innovation Council
Awarded for innovative solutions in agricultural biotechnology and sustainable practices.

Bioinformatics Society
Recognition for pioneering work in computational biology and molecular modeling.

Biotech Innovation Summit
Celebrating Mr Biologist as an emerging leader in the biotechnology and bioinformatics industry.
Our in-house R&D programs reflect our focus on sustainability, biotechnology innovation, and applied microbiological research. Each project is designed to generate scientific insight with real-world value.





Six water samples collected from different sites along the Bharalu River are being analyzed using metagenomic sequencing to profile microbial communities. 16S rRNA-based identification and enzyme activity studies are underway to assess the ecological and biotechnological potential of these isolates.
Impact
Revealing microbial diversity for cleaner water and environmental sustainability.





Microbial strains from traditional rice wine starter cultures have been isolated and identified—six bacterial and two fungal species—followed by biochemical and enzymatic profiling. Ongoing work examines their role as potential functional food microbes.
Impact
Preserving indigenous fermentation knowledge through modern microbiological research.

This study employs Azadirachta indica (neem) extract as a natural reducing and stabilizing agent for zinc oxide nanoparticle synthesis. Characterization confirms promising antioxidant and antimicrobial properties, supporting eco-friendly nanomaterial development.
Impact
Advancing sustainable nanotechnology through plant-based synthesis routes.
Our diverse team of scientists and researchers brings together decades of experience in computational biology, molecular biology, and bioinformatics to deliver breakthrough results.
We're always looking for talented researchers and scientists to join our mission of advancing scientific discovery through computational excellence.
At Mr Biologist LLP, we believe that real learning happens through hands-on experience. Our programs blend wet-lab skills, in-silico learning, and one-on-one mentorship to build confident, capable researchers.
Our training and internship programs are designed for students and young researchers who want to gain practical laboratory and computational skills while learning how to think, plan, and write like real researchers. Whether you’re taking your first step or advancing your expertise, our programs combine wet-lab techniques, in-silico learning, and one-on-one mentorship from experienced professionals — helping you build confidence and real research capability.
Our internships are tailored to help participants understand and practice the entire research process. Interns are guided through every stage — from idea generation to data interpretation and report preparation.
Introduction to Mr Biologist LLP’s research environment, safety protocols, and available project areas. Participants select or are assigned a topic based on their interests and background.
Practical sessions in the lab or through bioinformatics platforms — learning experimental design, data analysis, and tool application.
Guided mentorship ensures participants understand scientific methodology, troubleshooting, and result interpretation.
Participants prepare a research report or dissertation and deliver a short presentation summarizing their findings and learnings.
Training participants receive a Certificate of Completion; internship participants receive a Certificate of Completion and an Experience Letter acknowledging research contribution and duration.
We collaborate with universities, research institutions, and biotech startups to conduct joint workshops, specialized training sessions, and internship programs. These collaborations bring industry-aligned exposure and project-based learning directly to students and campuses across India.
Be part of a growing community of researchers and innovators. Join Mr Biologist LLP to learn, explore, and grow in the exciting world of biosciences!
Hear from researchers and institutions who have experienced our training and services.
It's one of the best trainings I ever attended, Dr.Vaibhav was very nice, smart and took everyone along, even after the training he was still answering my questions. It was an interesting period for me
I previously tried many Youtube channels on taught as simple as you did, learn many things about Homology modelling from your workshop. Thank you for the sessions Mr Biologist team and special thanks to Dr.Vaibhav sir, with lot of patience he thought us many things is short duration of time
It was so educating, it exposed and taught me important data base and how to use. My quest in drug discovery using target oriented approcah had been taken to the next level
Experience the same quality training and support that has helped hundreds of researchers advance their careers.